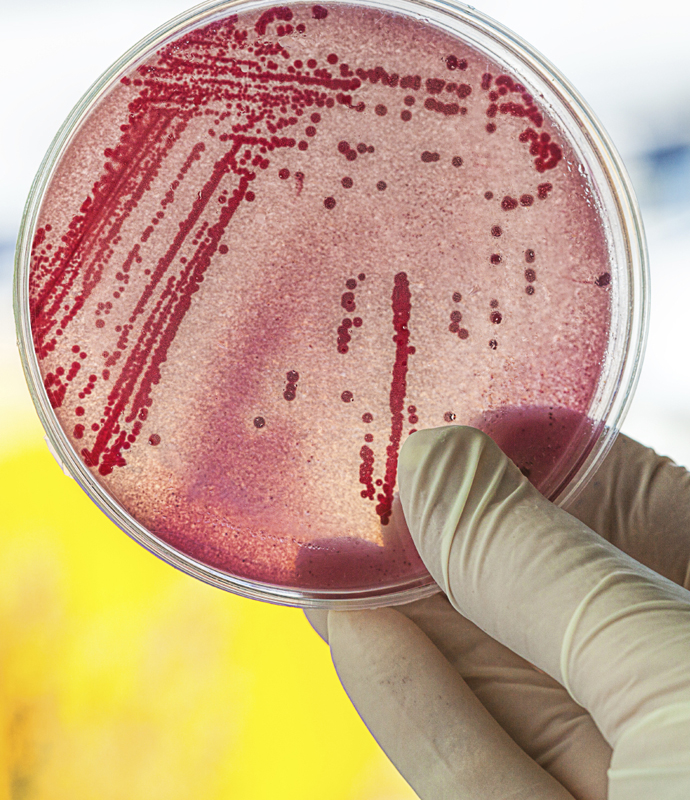
Air-Sampling-for-Bacteria
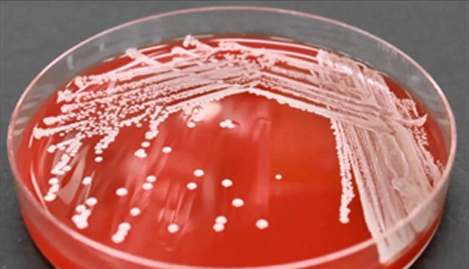
10477
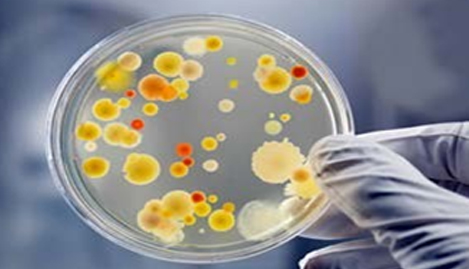
10478

- Bacteria sampling is generally completed because there was a toilet overflow, sewer system backup or break in the building’s
- Sometimes, bacteria test data is used to “confirm the presence” of fecal coliforms, including their location; where after building and content cleanup and disinfection, bacteria tests are used to “confirm the absence” of fecal coliforms including target microorganisms, such as Escherichia coli (E. coli). Note: air sampling of fecal coliform bacteria may not be
Bacteria Screening and Analysis Methods
- Because the human eye cannot see potentially harmful pathogens (disease causing microorganisms), the technician must be allowed to collect a representative set of samples to quantify when surfaces are clean or
- Culture analysis methods include petri dishes and an agar (media that allows bacteria to colonize), that are incubated for 48 to 72-hours before
- Depending on the situation and contamination, we request our labs to use Colilert 18 for the simultaneous detection for the presence/absence of total coliforms and Escherichia coli.
- When practical, we ask labs to use MUG analysis. MUG is an acronym for “4-methylumbellferyl-beta-D-glucuronide.” EPA approved MUG analysis as an effective method for detection and verification of coli in food, water, and environmental samples, for presence/absence of fecal coliforms.